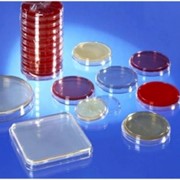

Среда С Маннитом И Желчью

🛑 👉🏻👉🏻👉🏻 ВСЯ ИНФОРМАЦИЯ ДОСТУПНА ЗДЕСЬ, ЖМИ 👈🏻👈🏻👈🏻
Селективная среда с маннитом и желчью 100 г .
Селективная среда с маннитом и желчью (фасовка 0,1 кг . . .
Селективная среда с маннитом и желчью - ООО "Синтэкс"
Селективная среда с маннитом и желчью купить по цене 6 руб . . .
G06200001 Селективная Среда С Маннитом И Желчью, Расход . . .
СРЕДА питательная СЕЛЕКТИВНАЯ с маннитом и желчью
Селективная среда с маннитом и желчью 0,1 кг, цена в . . .
Селективная среда с маннитом и желчью 0,5 кг, цена в . . .
Селективная среда с маннитом и желчью / interlab .by
Среда селективная с желчью для чего она
Мавирет Препарат Цена Отзывы
Бад Альфа Липоевая Кислота Отзывы
Линкас Цена Омск
biokompas-s .ru › selektivnaja-sreda-s-mannitom-i-zhelchju
В качестве селективных агентов, наряду с маннитом и бычьей желчью, в этой среде используются полимиксин, а также индикаторная система кристаллвиолет - бромтимоловый синий . Фасовка в пластиковые банки по 100 г . Расход среды 50 г/дм3 . Цена дана за 1 упаковку с учетом НДС 20 % . Рекомендуемые товары Селективная среда с маннитом и желчью 500 г .
Селективная среда с маннитом и желчью (фасовка 0,1 кг) - купить в интернет-магазине оптом и в розницу недорого . Гарантия качества от производителя, большой ассортимент, выгодные цены, доставка по всей России .
www .npfsyntex .ru › selektivnaya-sreda-s-mannitom-i-zhelchyu
Сухая питательная среда применяется для приготовления жидкой селективной среды по ГОСТ 28560-90 (п . 3 .2 .3); в качестве селективных агентов, наряду с маннитом и бычьей желчью, в этой среде используются полимиксин, а также . . .
Селективная среда с маннитом и желчью продажа от официального дистрибьютора товаров медицинского назначения ООО «ИНКО» в Санкт-Петербурге . Доставка по всей России . Постоянное наличие на складе ассортимента
G06200001 Селективная среда с маннитом и желчью, расход среды 50 г/дм3, 0,5 кг в интернет-магазине Germeon от производителей . Высокое качество, честность, надежность . Доставка по Санкт-Петербургу, области и всей России .
СРЕДА питательная СЕЛЕКТИВНАЯ с маннитом и желчью . Внимание Все питательные среды поставляются только в упаковке изготовителя!
Селективная среда с маннитом и желчью 0,1 кг по цене 1 300 руб . в Ижевске . Условия доставки и оплаты от компании 18agro .ru .
Селективная среда с маннитом и желчью 0,5 кг по цене 5 720 руб . в Ижевске . Условия доставки и оплаты от компании 18agro .ru .
Селективная среда с маннитом и желчью и любые другие питательные среды . Купить в Минске . Доставка по Беларуси или самовывоз . Низкие цены .
Вы можете задать любой интересующий вас вопрос по товару или работе магазина . Селективная среда с маннитом и желчью (фасовка 0,1 кг) Отзывы о товаре Задать вопрос
Лазолван Применение Внутрь
Дексалгин 2 Мл Уколы Цена 5 Ампул
Тизоль С Витамином А
Какая Реакция На Пентаксим
Далацин 40г Крем
Индометацин В Ампулах Для Внутримышечного
Вильпрафен Антибиотик Суспензия
Хумалог Микс Какого Действия
Прегнотон Отзывы При Планировании Форум
Ксарелто В Аптеках Нижневартовска
Вольтарен Гель Цена В Томске
Нейромидин И Резолор Вместе
Крем От Аллергии Фенистил
Везикар Отзывы Женщин При Недержании Мочи
Корилип Свечи При Ацетоне
Лекарства Синупрет Применение
Золофт И Его Аналоги Отзывы Рейтинг
Хлорелла И Спирулина Разница
Дексаметазон Уколы Внутривенно При Пневмонии
Гликлазид 60 Цена Отзывы
Какой Телефон У Снуп Дога
Гипорамин При Коронавирусе Отзывы
Сорбекс Цена В России
Називин Для Новорожденных Форум
Пирацетам 10 0
Хофитол Цена В Кургане
Отривин Соплеотсос Фото
Пеметрексед Рак Яичников
Таблетки От Сухого Кашля Для Взрослых
Оленьи Рожки Каланхоэ Лациниата
Одестон И Урсосан Совместимость
Золототысячник Лекарственное Растение
Цитофлавин Таблетки Цена В Ростове На Дону
Дюфастон С 10 Дня Цикла
Парацетамол От Боли В Горле
Лекарство Номидес Инструкция По Применению
Нимесулид Детям 3 Года
Венарус От Синяков Отзывы
Фолиевая Кислота Для Беременных Цена В Аптеках
Диосмектит Аналог Смекты
Троксевазин Нео Отзывы Цена
Тобрекс При Синусите Отзывы
Престанс Делимые Ли Таблетки
Почему Сняли С Производства Таблетки Лозап
Чем Отличается Стопдиар От Энтерофурила
Феназепам Что Это Простыми Словами
Элицея Инструкция Отзывы Принимавших Препарат Цена
Ибупрофен 400 Цена СПб
Кордафлекс Понижает Давление
Что Дает Лактофильтрум Организму
Водный Раствор Календулы
Мильгамма При Радикулите
Аптека Ру Урсосан 250
Дезринит Спрей Назальный Отзывы При Насморке
Тербинафин Крем Молочница
Кагоцел Бесплодие У Мужчин Правда
Формидрон Где Применяется
Монурал Отпускается
Пентас Цветок Отзывы Выращивание
Йодинол Зеленый
Сотрешь Спряжение
Нормобакт Апрель Аптека
Церукал Помогает От Тошноты Отзывы
Кальция Карбонат Для Диализа
Успокоительные Таблетки Эвалар Форте
Курантил При Планировании Беременности Отзывы
Сколько Принимать Фолиевой Кислоты
Рибоксин Рлс
Дексалгин Мазь Цена Аналоги
Феринжект Побочные
Паклитаксел Отзывы При Рмж
Избыток Кальция В Рационе
Фемостон 1 10 Аналоги Цена
Голдлайн При Грудном Вскармливании Отзывы
Назонекс Курск
Как Заваривать Календулу
Крем Овипол Клио Инструкция
Нео Пенотран Свечи Цена В Краснодаре
Термопсис Ланцетный При Беременности
Цефтриаксон Боль
Из Таблетки Гидроперита 3 Перекись Водорода
Омега 3 6 9 Доппельгерц Применение
Магнилайн Показания К Применению
Урсосан В Таблетках 500
Траумель Поможет От Синяков
Индапамид При Низком Давлении
Таблетки Левитра Цена
Ультоп Цена 20 Мг 28 Таблеток
Глюкозамин Хондроитиновый Комплекс Капс 90 Шт Отзывы
Фемостон Конти Инструкция Отзывы Женщин
Лекарственный Препарат Триметазидин Инструкция По Применению
Какой Варфарин Лучше
Випросал Мазь Цена В Гомеле
Уриклар Аналоги Препарата
Местамидин Спрей При Ангине
Климонорм В Испании
Энтерофурил Цена В Уфе Фармленд
Хлорид Железа 3 Сульфат Калия
Нак Екатеринбург
Сетевой Город Мирный Якутия Войти Через Госуслуги
Среда С Маннитом И Желчью























.jpg)







.jpg)